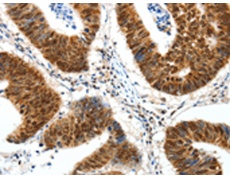
一抗

|
Background: |
The protein encoded by this gene is a zinc finger transcription factor that binds to GC-rich motifs of many promoters. The encoded protein is involved in many cellular processes, including cell differentiation, cell growth, apoptosis, immune responses, response to DNA damage, and chromatin remodeling. Post-translational modifications such as phosphorylation, acetylation, glycosylation, and proteolytic processing significantly affect the activity of this protein, which can be an activator or a repressor. Three transcript variants encoding different isoforms have been found for this gene. |
|
Applications: |
ELISA, IHC |
|
Name of antibody: |
SP1 |
|
Immunogen: |
Synthetic peptide of human SP1 |
|
Full name: |
Sp1 transcription factor |
|
SwissProt: |
P08047 |
|
ELISA Recommended dilution: |
2000-5000 |
|
IHC positive control: |
Human colon cancer and Human ovarian cancer |
|
IHC Recommend dilution: |
50-200 |

 購(gòu)物車
購(gòu)物車 幫助
幫助
 021-54845833/15800441009
021-54845833/15800441009